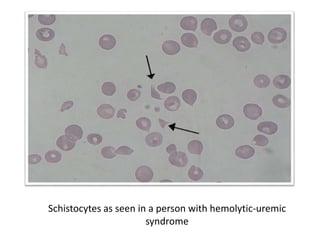
Schistocytes as seen in a person with hemolytic-uremic
syndrome

Hemolytic-uremic syndrome (HUS) is a disease characterized by hemolytic anemia, low platelet count, and kidney failure. It is predominantly seen in children and can be caused by infections from E. coli or other bacteria. There are typical and atypical forms of HUS. The typical form is usually caused by Shiga toxin-producing bacteria and their toxins damaging the endothelial cells in the kidneys and other organs. Atypical HUS is linked to genetic complement factor abnormalities. Treatment involves supportive care, antibiotics if infection is present, and plasma therapy to replace deficient complement factors for atypical cases. Most patients survive the acute phase but some may have long-term kidney or other organ damage.